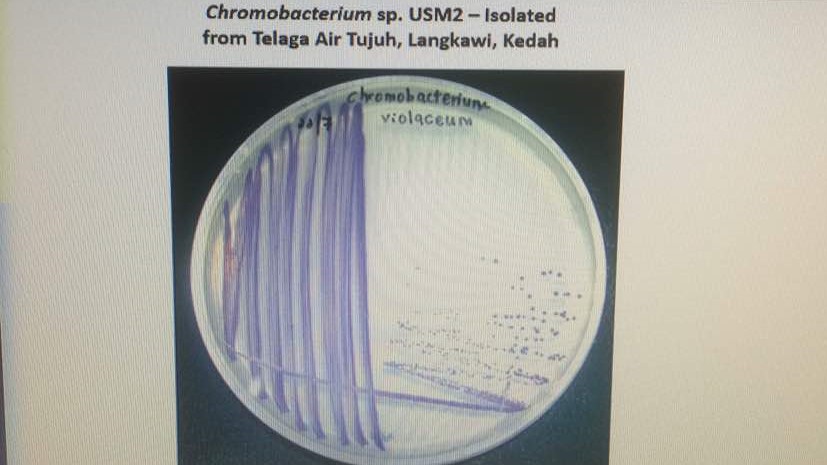

Kerjasama dengan penyelidik daripada Institut Sains dan Teknologi NARA (NAIST) di Jepun, penemuan yang ketara telah dicapai di dalam penyelidikan untuk membangunkan plastik mesra alam sekitar dan lestari yang dikenali sebagai PHA.
Plastik telah lama dikenalpasti sebagai bahan yang memberi kesan jangka panjang kepada alam sekitar. Plastik yang dibuang akan kekal di persekitaran untuk berdekad dan mungkin beratus tahun kerana sifatnya yang tidak terurai.
Ia mengambil masa berdekad untuk menangani cabaran ini. Walaubagaimanapun, penemuan yang diterbitkan baru-baru ini di dalam jurnal berimpak tinggi “Nature Science Reports” oleh sekumpulan penyelidik daripada Universiti Sains Malaysia dan NAIST telah mengenalpasti mikrob yang dijumpai di kawasan setempat yang boleh menghasilkan molekul plastic. “Bioplastik ini boleh terurai dengan senang seperti bahan organik yang lain.
Mikrob ini, yang dijumpai di Telaga Tujuh, Langkawi, Kedah mempunyai enzim yang dipanggil sintes PHA, membolehkan unit kecil bahan kimianya bersama-sama membentuk rantaian molekul plastik yang sangat panjang.
Sintes PHA yang dijumpai oleh penyelidik USM mempunyai kadai aktivti yang paling tinggi berbanding dengan enzim yang sama yang dilaporkan setakat ini. Buat masa ini, beberapa makmal utama di Eropah, Amerikat Syarikat dan Jepun juga berlumba-lumba untuk mencari kefahaman yang lebih baik mengenai enzim sintes PHA.
Apabila struktur molekur telah dikenalpasti, ia boleh digunakan untuk menghasilkan bahan baru untuk plastic yang boleh terurai dan mesra alam sekitar. Bermula dengan mengenalpasti mikrob dan mengasingkan gen sintes PHA untuk menghasilkan enzim dan akhirnya menentukan struktur proteinnya, penyelidik USM akhirnya Berjaya melakukannya melalui kerjasama antarabangsa.
Berita lanjut di http://news.usm.my/index.php/english-news/5046-usm-naist-discovers-local-microbe-to-eliminate-plastic-waste
Sumber :- http://www.majalahsains.com/kerjasama-usm-naist-bangunkan-plastik-mudah-urai-dan-mesra-alam/

